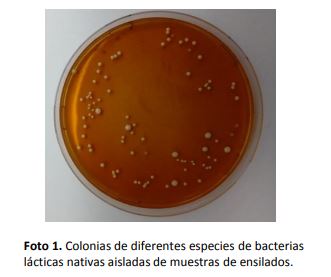

Los inoculantes comerciales para ensilados contienen mayormente bacterias lácticas (BAL) que inician y dominan el proceso de fermentación, disminuyendo rápidamente el pH de la masa vegetal mediante la producción de ácido láctico. Dentro de este grupo de bacterias hay algunas especies que además son capaces de producir ácido acético, el cual inhibe el crecimiento de hongos y levaduras, mejorando así la estabilidad aeróbica del silo una vez abierto. El INTA y el Instituto de Lactología Industrial de la Universidad Nacional del Litoral han caracterizado BAL aisladas de material para ensilar con el objetivo de seleccionar aquellas bacterias capaces de fermentar rápidamente e inhibir el desarrollo de microorganismos alteradores tales como hongos y levaduras (Foto 1).
Las bacterias lácticas (BAL) constituyen un grupo muy diverso de microorganismos y se encuentran ampliamente distribuidas en la naturaleza. Debido a su capacidad fermentativa y de transformación de sustratos, son utilizadas en la producción y conservación una amplia gama de alimentos. Entre sus numerosas aplicaciones se encuentra la conservación de forrajes (pasturas, granos y verdeos) para la alimentación del ganado mantenido bajo sistemas de cría intensivos (Foto 2).
Este método de conservación, denominado ensilado, se basa en la fermentación del material vegetal por estas bacterias que consumen los azúcares presentes en la pastura y los transforman en ácidos orgánicos (ácido láctico principalmente y ácido acético en menor medida), disminuyendo el pH y logrando la estabilización de la masa vegetal y la inhibición de microorganismos perjudiciales (como clostridios, hongos y levaduras).
Esta fermentación puede ser llevada a cabo por las BAL naturalmente presentes en el material a ensilar, o puede inducirse mediante el agregado de inoculantes microbianos conformados por una o más de estas bacterias, lográndose así beneficios nutricionales y económicos en relación a la fermentación espontánea. Se identificaron por métodos de biología molecular 125 bacterias lácticas aisladas de 51 muestras de diferentes materiales para ensilar (trigo, alfalfa, maíz, etc.).
De estos aislamientos, 52 fueron la especie de BAL más utilizada en la formulación de inoculantes comerciales para silos (Lactobacillus plantarum) por su rápida producción de ácido láctico y 35 fueron de especies que producen ambos ácidos (láctico y acético). Las pruebas de caracterización de BAL realizadas en microsilos por el INLAIN permitieron encontrar cepas de L. plantarum con potencial para ser utilizadas en la formulación de un inoculante para silos por su habilidad para reducir el pH del silo a valores menores a 4 luego de 2 a 3 días de ser inoculadas. Por otro lado, en microsilos donde se evaluó la capacidad para inhibir microorganismos alteradores, se preseleccionaron 5 bacterias lácticas capaces de producir ambos ácidos y así evitar la multiplicación de hongos y levaduras (Foto 3).
Estos resultados demuestran que las bacterias lácticas nativas aisladas de materiales para ensilar tienen potencial para ser utilizadas en la formulación de un inoculante para silos. En futuros ensayos se tratará de determinar si estas bacterias pueden ser secadas por método spray manteniendo tanto su viabilidad como sus características fermentativas. De esta manera se las podrá fabricar en polvo para ser comercializada como la mayoría de los inoculantes para silo del mercado.
Fuente: INTA por Mónica del Carmen Gaggiotti, Gabriela María Audero, Roxana Beatriz Paez, Luis Alberto Romero, Ariel Fernando Massera